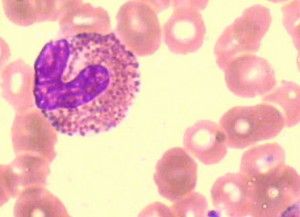
嗜酸性粒細胞數
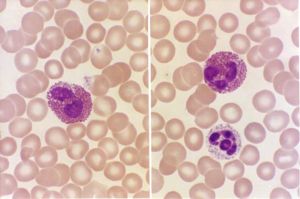
嗜酸性粒細胞數

嗜酸性粒細胞數

嗜酸性粒細胞數,血中嗜酸性粒細胞也來源於多能幹細胞,在細胞的前體(precursors)階段已能與其他髓系細胞區別,體外培養可分離出嗜酸性粒細胞祖細胞(eosinophil committed cell)。血中嗜酸性粒細胞量在晝夜有明顯變化,清晨較低,夜間較高。其周期變化與血中腎上腺皮質的糖皮質激素呈負相關,糖皮質激素升高,嗜酸性粒細胞減少;反之,嗜酸性粒細胞則升高。嗜酸性粒細胞的胞質內含有嗜酸性顆粒,早期嗜酸性粒細胞所含的顆粒較大,後期細胞所含的顆粒較小。
基本信息
- 所屬分類:血
- 相關疾病:妊娠性哮喘等
- 相關症狀:類風濕關節炎、嗜酸細胞增加
正常值
血細胞自動計數儀:(50-300)×10/L(50-300/mm)。臨床意義
 嗜酸性粒細胞數(1)嗜酸性粒細胞增多:①過敏性疾患:支氣管哮喘、蕁麻疹、結節性多動脈炎、藥物過敏、血清病等。②皮膚病:天皰瘡、皰疹性皮炎、痒疹、多形性滲出性紅斑、濕疹等。③寄生蟲病:蛔蟲病、鉤蟲病、血吸蟲病、肺吸蟲病、囊蟲病等。④感染症:猩紅熱、麻疹潛伏期、呂弗琉(L?ffler)綜合徵、感染性疾病恢復期等。⑤血液病:嗜酸性粒細胞性白血病、慢性粒細胞性白血病、霍奇金病、惡性貧血、家族性嗜酸粒細胞增多症、熱帶性及非熱帶性嗜酸細胞增多症、骨髓纖維化、器官移植排斥反應等。⑥其他:放射線照射後、卵巢腫瘤、肉樣瘤病、腎上腺皮質功能減退症等。 (2)嗜酸性粒細胞減少:①感染:傷寒、副傷寒、套用糖皮質類固醇激素等。②藥物:用ACTH、腎上腺皮質激素後等。③應激狀態。
嗜酸性粒細胞數(1)嗜酸性粒細胞增多:①過敏性疾患:支氣管哮喘、蕁麻疹、結節性多動脈炎、藥物過敏、血清病等。②皮膚病:天皰瘡、皰疹性皮炎、痒疹、多形性滲出性紅斑、濕疹等。③寄生蟲病:蛔蟲病、鉤蟲病、血吸蟲病、肺吸蟲病、囊蟲病等。④感染症:猩紅熱、麻疹潛伏期、呂弗琉(L?ffler)綜合徵、感染性疾病恢復期等。⑤血液病:嗜酸性粒細胞性白血病、慢性粒細胞性白血病、霍奇金病、惡性貧血、家族性嗜酸粒細胞增多症、熱帶性及非熱帶性嗜酸細胞增多症、骨髓纖維化、器官移植排斥反應等。⑥其他:放射線照射後、卵巢腫瘤、肉樣瘤病、腎上腺皮質功能減退症等。 (2)嗜酸性粒細胞減少:①感染:傷寒、副傷寒、套用糖皮質類固醇激素等。②藥物:用ACTH、腎上腺皮質激素後等。③應激狀態。
注意事項
白細胞分類受技術因素和細胞分布因素等原因而有較大變異,故分類計數的離散度較大,且分類中占大比例的如中性粒細胞及淋巴細胞變異呈常態分配,占小比例的如嗜酸粒細胞、嗜鹼粒細胞及單核細胞呈普哇松分布。根據Rümke等研究,白細胞分類計數的95%及99%可信限範圍,可參見下表(表1)查得。例如某血片作200個白細胞分類,其中粒細胞為60%(p),其他細胞為40%(q),則出現p可能性的標準誤(SEp)為,n為計數的細胞數,查表Low95%及High95%行與p60,q40列,相交處得53及67,即本例分類95%可信限最低為53%,最高為67%,同理99%可信限為51%-69%。也即對同份血片或同一病人的另一張血片再作白細胞分類計數時,有95%的可能性,粒細胞的分類計數範圍在53%-67%,99%的可能性範圍為51%-69%。超出此範圍的即認為分類計數誤差過大,不符質量要求,應予重視。
相關疾病
自身免疫性胰腺炎,皮膚頜口蟲病,過敏性肉芽腫性血管炎相關鞏膜炎,妊娠性哮喘,激素抵抗型哮喘,細粒棘球蚴病,四川並殖吸蟲病,片吸蟲病,廣州管圓線蟲病,陰道美麗筒線蟲病。
相關症狀
嗜酸細胞增加,類風濕關節炎。
 嗜酸性粒細胞數
嗜酸性粒細胞數
嗜酸性粒細胞數
嗜酸性粒細胞數